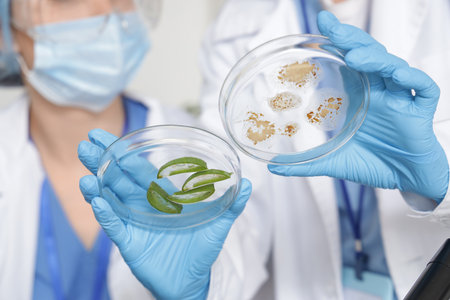
Female scientists with Petri dishes in laboratory, closeupの写真素材

写真素材 - Female scientists with Petri dishes in laboratory, closeup
キーワード
- adult
- analysis
- background
- biological
- biotechnology
- care
- chemical
- chemistry
- closeup
- development
- dish
- dishes
- doctor
- equipment
- experiment
- female
- glass
- health
- indoors
- industry
- job
- lab
- laboratory
- medical
- medicine
- microbiology
- modern
- occupation
- people
- person
- petri
- pharmaceutical
- profession
- research
- sample
- science
- scientific
- scientists
- specialist
- studying
- technology
- test
- uniform
- virus
- woman
- women
- work
- working
- young
類似作品
Portrait of fem...
A pastry chef m...
Two scientists ...
milk factory pr...
Making Face Bea...
Laboratory for ...
Step into the f...
Biological wome...
Researcher woma...
Food safety ins...
Chemical Labora...
A woman in lab ...
Team Asian scie...
milk factory pr...
Microbiologists...
Housework: youn...
A scientist con...
Chemical Labora...
Professional Fe...
Two chefs use d...
Female scientis...
Scientist pipet...
Two surgeons wa...
Scientist worki...
Young female sc...
Beautiful girl ...
female muslim s...
Woman waitress ...
Pretty, young w...
medical marijua...
Biomedical Engi...
A man in a whit...
Waist up portra...
Chemical Labora...
Team Asian scie...
Portrait of a h...
Team of scienti...
A good-looking ...
Confident woman...
woman in mask, ...
A scientific me...
partial view of...
A state-of-the-...
Female chef exa...
Blood testing e...
Chemical Labora...
Hands in purple...
Little baby gir...